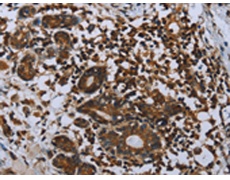
一抗

別 名: CRL; GPL; CRL3; GLMR; GLM-R; PLCA2; hGLM-R; IL-31RA; PRO21384
反應(yīng)種屬: Human
標(biāo) 記 物: Unconjugate
克隆類型: rabbit polyclonal
|
Background: |
The protein encoded by this gene belongs to the type I cytokine receptor family. This receptor, with homology to gp130, is expressed on monocytes, and is involved in IL-31 signaling via activation of STAT-3 and STAT-5. It functions either as a monomer, or as part of a receptor complex with oncostatin M receptor (OSMR). Several alternatively spliced transcript variants encoding different isoforms have been noted for this gene. |
|
Applications: |
ELISA, IHC |
|
Name of antibody: |
IL31RA |
|
Immunogen: |
Fusion protein of human IL31RA |
|
Full name: |
interleukin 31 receptor A |
|
Synonyms: |
CRL; GPL; CRL3; GLMR; GLM-R; PLCA2; hGLM-R; IL-31RA; PRO21384 |
|
SwissProt: |
Q8NI17 |
|
ELISA Recommended dilution: |
1000-2000 |
|
IHC positive control: |
Human breast cancer and human prostate cancer |
|
IHC Recommend dilution: |
25-100 |

 購物車
購物車 幫助
幫助
 021-54845833/15800441009
021-54845833/15800441009